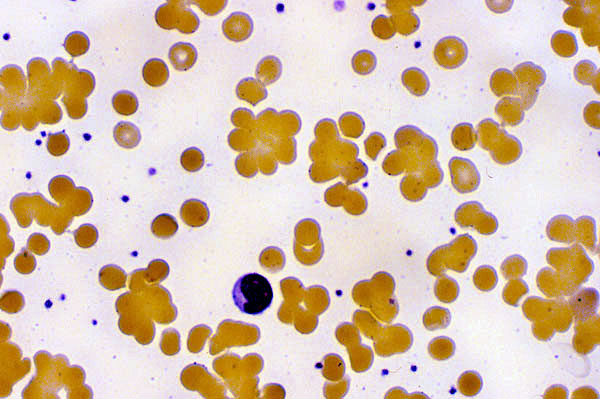

Red blood cell agglutination, peripheral blood smear
Click picture to enlarge. Close window to return
The red blood cells are present in cell clumps, which in this case is due to the presence of a cold agglutinin. Monoclonal IGM binds RBCs and causes their agglutination at a temperature of 37 oC.